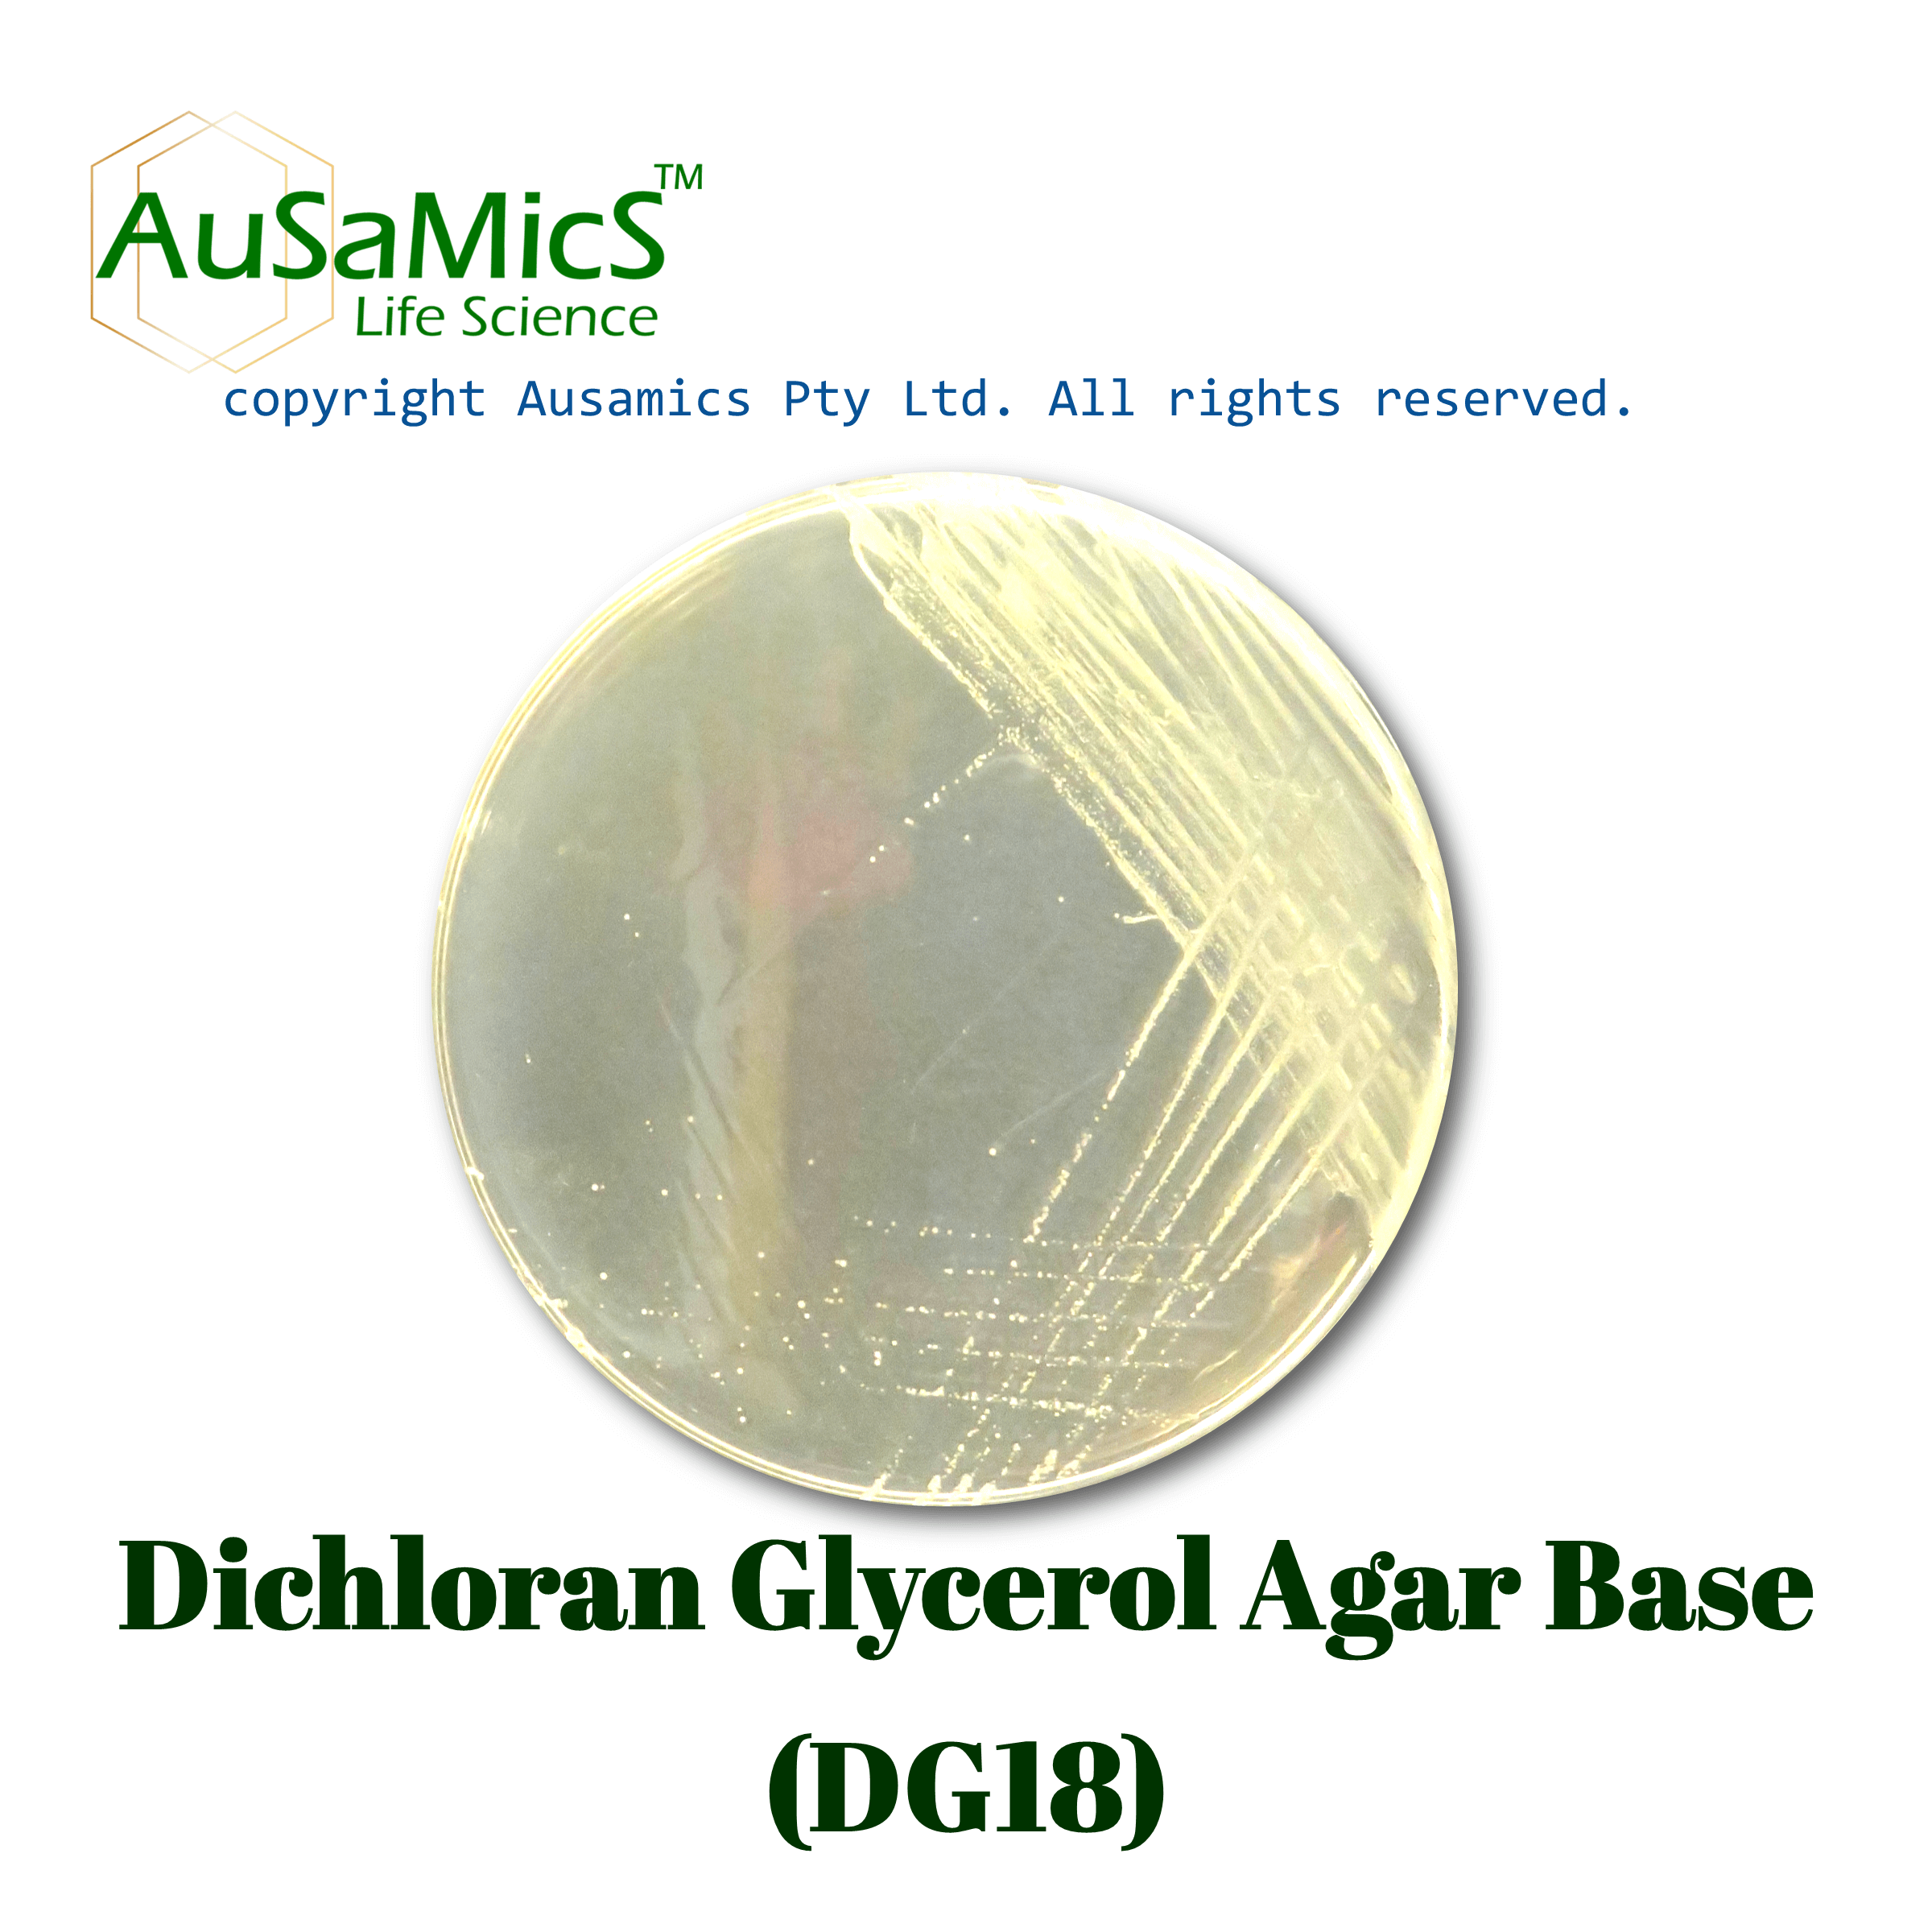
DG18_Ausamics
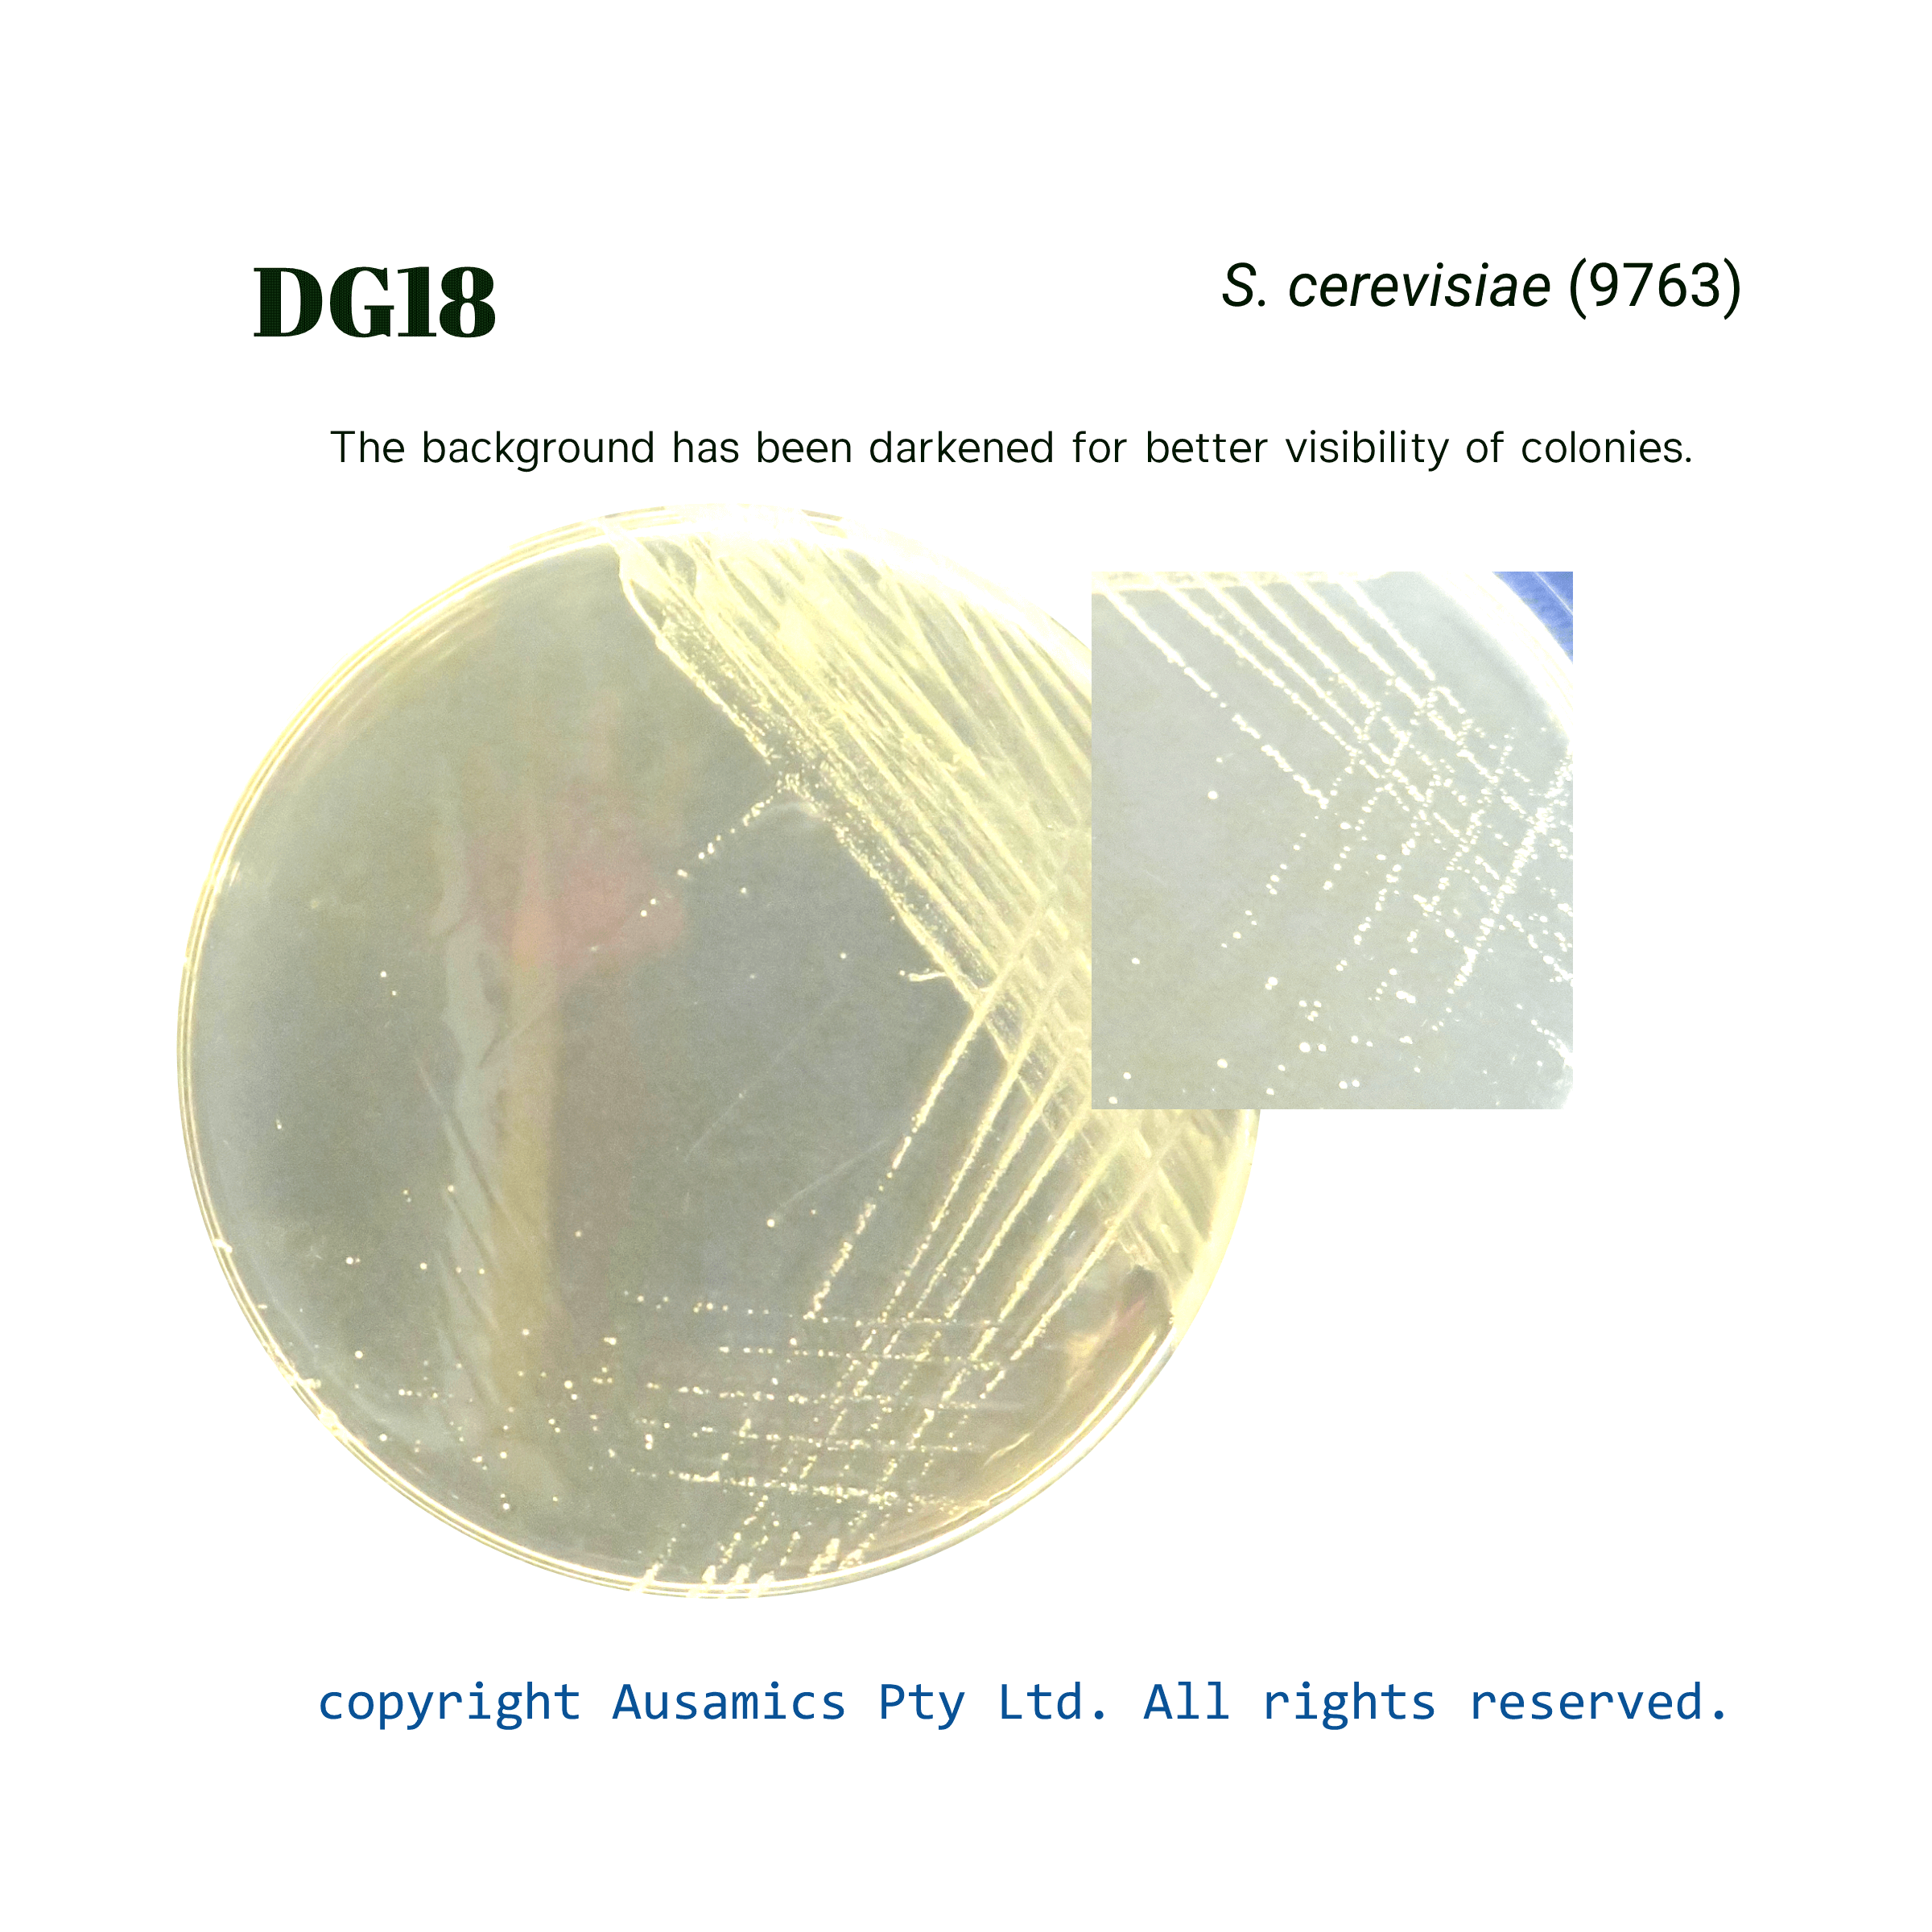
DG18_Scerevisiae(9763)_Ausamics

Dichloran-Glycerol Agar, DG18
For use as a general-purpose medium for counting yeast and molds in food items, as well as for the counting and isolation of xerophilic molds in dry and semidried foods.
- Description
- Composition
- Quality Control
- Microbial Test Results
A selective culture medium called Dichloran Glycerol Agar (DG18) is intended for the counting and isolation of xerophilic molds. The medium’s water activity (aw) is decreased to about 0.95 by adding 18% glycerol, which prevents bacterial growth while promoting fungal development. Bacterial contaminations are further suppressed by chloramphenicol. Dichloran prevents mucoraceous fungi from growing excessively, which makes accurate colony counts easier. Peptone and dextrose ensure that nutrients are provided; potassium phosphate buffers the medium and magnesium sulfate provides necessary ions. DG18 is mostly utilized in clinical mycology but is also applied in the microbiological study of semi-dried and dried food products.
Storage
Keep the container at 15-30 °C and prepared medium at 2-8 °C.
| Composition | gr/L |
| Peptone from Casein | 5 |
| Glucose | 10 |
| Potassium Dihydrogen Phosphate | 1 |
| Dichloran | 0.002 |
| Magnesium Sulfate | 0.5 |
| Chloramphenicol | 0.1 |
| Agar | 15 |
| Final pH at 25°C | 5.6 ± 0.2 |
| Dehydrated Appearance | Homogeneous, free flowing, and beige. |
| Prepared Appearance | Prepared medium is trace to slightly hazy and beige. |
| Reaction of 3.16% Solution at 25°C | pH 5.6 ± 0.2 |
| Incubate at 22 to 25 °C for up to 5 to 7 days. | |
| Organism (ATCC) | Recovery |
| Saccharomyces cerevisiae (9763) | Good/Very good |
| Mucor racemosus (42647) | Fair/ Good |
| Bacillus subtilis (6633) | None |
| Escherichia coli (25922) | None |